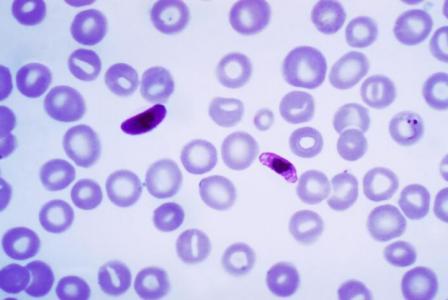
Le paludisme cérébral frappe plus de 575.000 personnes chaque année, et, de manière disproportionnée les jeunes enfants vivant en Afrique subsaharienne

PALUDISME : Découverte de la protéine responsable des fuites cérébrales
Cette découverte d’une équipe de l’University of Utah Health ouvre une nouvelle voie thérapeutique dans la lutte contre la forme de paludisme la plus meurtrière, le paludisme cérébral, une complication mortelle qui entraîne des dommages au cerveau. Les scientifiques américains, en collaboration avec les chercheurs de l’Institut Pasteur au Cameroun, identifient une molécule clé qui se révèle une cible prometteuse de nouveaux médicaments, alors que peu traitements sont disponibles pour traiter cette forme cérébrale de la maladie tropicale. Ces travaux, présentés dans la revue PLOS Pathogens, annoncent une nouvelle stratégie thérapeutique pour prévenir cette forme mortelle chez l'Homme.
Le paludisme cérébral frappe plus de 575.000 personnes chaque année, et, de manière disproportionnée les jeunes enfants vivant en Afrique subsaharienne. Cette maladie tropicale provoque des fuites vasculaires dans le cerveau et le coma, avec un taux moyen de décès de 20%. Parmi les survivants, 80% développent des symptômes neurodéveloppementaux dont des convulsions et des troubles de santé mentale.
La perturbation de la barrière hémato-encéphalique est une étape critique dans la pathogenèse du paludisme cérébral et ses conséquences dramatiques. La barrière hémato-encéphalique est constituée de cellules qui tapissent les vaisseaux sanguins et s'emboîtent étroitement, s'assemblant en une barricade. La paroi cellulaire semi-perméable empêche, normalement, les fluides du système nerveux de se mélanger à la circulation sanguine tout en laissant passer les métabolites essentiels.
Une protéine, EphA2, impliquée dans la fuite vasculaire et l'hémorragie
En étudiant la maladie chez des modèles souris, les chercheurs constatent qu’une protéine, EphA2 est activée au site de la barrière hémato-encéphalique juste avant sa dégradation. Une recherche plus approfondie confirme qu’EphA2 perturbe la barrière hémato-encéphalique en desserrant ces jonctions serrées entre les cellules, en supprimant la liaison qui maintient ces cellules « collées » les unes aux autres. EphA2 est donc une molécule clé impliquée dans la fuite vasculaire et l'hémorragie, des symptômes caractéristiques du paludisme cérébral.
Bloquer la protéine avec différents médicaments empêche le développement de cette complication : pour preuve, le traitement de souris infectées avec 2 agents différents (le Nilotinib, ainsi qu’une protéine modifiée qui bloque spécifiquement des ligands d'éphrine qui interagissent avec EphA2 et empêchent son activation). « Une avancée vraiment significative », commente l’auteur principal, le Pr Tracey Lamb, agrégé de pathologie à l'Université d'Utah : « De nouvelles cibles pour bloquer ces micro-fuites vasculaires dans le paludisme sont nécessaires de toute urgence pour prévenir la mortalité liée à cette forme de paludisme ».
Ces 2 thérapies s’avèrent efficaces jusque 4 jours après l'infection : cela suggère qu’elles n’auraient pas à être données à titre préventif, ce qui peut être complexe en situation réelle. Car les enfants viennent en clinique lorsqu’ils présentent déjà les symptômes de la maladie. Ces deux thérapies s’avèrent également très prometteuses chez ces jeunes patients, car l’analyse de leur sang révèle des niveaux élevés de protéine d'éphrine qui se lie à EphA2.
Ces travaux laissent ainsi présager de nouvelles options thérapeutiques pour freiner les décès associés au paludisme dans le monde, concluent les chercheurs qui envisagent de futures études axées sur la modulation de l'activité de cette protéine chez l'Homme.
